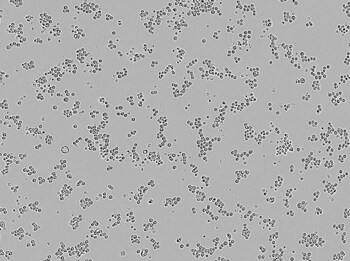
Brightfield image of MDA-MB-453 cells in culture, prior to transfection. Brightfield image of MDA-MB-453 cells in culture, prior to transfection.

Search
Search
| Component | Cat. No. |
|---|---|
| Gibco DMEM, with GlutaMAX Supplement | A3635201 |
| 10% Gibco FBS | A3160401 |
Proper culture techniques and procedures are an essential part of ensuring successful transfection. Subculturing, also referred to as passaging, is the removal of medium and transfer of cells from a culture into fresh growth medium, in order to propagate the cells.
Brightfield image of MDA-MB-453 cells in culture, prior to transfection.
| Component | Cat. No. |
|---|---|
| Invitrogen Lipofectamine 3000 Transfection Reagent | L3000008 |
| Gibco Opti-MEM I Reduced Serum Medium | 31985062 |
| Thermo Scientific Nunc Multidish, 24-Wells, Cell Culture Treated | 142475 |
On the day of transfection, which should be 1 day following cell plating, perform the following steps, which have been optimized for a single well of a 24-well plate using Invitrogen Lipofectamine 3000 Transfection Reagent:
| Step | Tube | Complexation components | Amount per well (24-well) |
|---|---|---|---|
| 1 | Tube 1 | Opti-MEM I medium | 25 μL |
| Lipofectamine 3000 reagent | 1.5 μL | ||
| 2 | Tube 2 | Opti-MEM I medium | 25 μL |
| DNA amount (DNA concentration should be 0.5–5 μg/μL) | 500 ng | ||
| P3000™ reagent | 1 μL | ||
| 3 | Add tube 2 solution to tube 1 and mix well | ||
| 4 | Incubate mixture from step 3 at room temperature for 10–15 min | ||
| 5 | Add 50 μL of complex from step 4 to cells; gently swirl plate to ensure homogeneous distribution of complex to the entire well | ||
At 48 hr following transfection of a GFP reporter construct, cells were evaluated via microscopy and flow cytometry. To assess transfection efficiency, cells were first visualized via fluorescence microscopy for qualitative assessment of protein expression, morphology, and viability (Figure 1). Cells were then prepared for flow cytometry by aspirating the medium and replacing it with 250 μL of a 7:3 mixture of TrypLE reagent:1X DPBS. Cells were incubated at 37°C for 10 min and then pipetted up and down to ensure single cells for flow cytometry analysis.
Figure 1. Posttransfection analysis of cells. (A) Fluorescence and (B) bright-field images demonstrating 54% transfection efficiency.
Use the following table to scale the volumes for your transfection experiment. The most common sizes are listed below.
| Culture vessel | Multiplication factor* | Shared reagents | DNA transfection | siRNA transfection | ||||
|---|---|---|---|---|---|---|---|---|
| Growth medium | Opti-MEM medium for complexing | DNA | P3000 reagent | Lipofectamine 3000 reagent** | siRNA | Lipofectamine 3000 reagent** | ||
| 96-well | 0.2 | 100 μL | 2 x 5 μL | 100 ng | 0.2 µL | 0.3 µL | 3 pmol | 0.3 µL |
| 48-well | 0.5 | 250 μL | 2 x 12.5 μL | 0.25 µg | 0.5 µL | 0.75 µL | 7.5 pmol | 0.75 µL |
| 24-well | 1 | 500 μL | 2 x 25 μL | 0.5 µg | 1 µL | 1.5 µL | 15 pmol | 1.5 µL |
| 12-well | 2 | 1 mL | 2 x 50 μL | 1 µg | 2 µL | 3 µL | 30 pmol | 3 µL |
| 6-well | 5 | 2 mL | 2 x 125 μL | 2.5 µg | 5 µL | 7.5 µL | 75 pmol | 7.5 µL |
| 60 mm | 11.05 | 5 mL | 2 x 250 μL | 5.5–11 µg | 11–22 µL | 16.5 µL | 166 pmol | 17 µL |
| 10 cm | 28.95 | 10 mL | 2 x 500 μL | 14–28 µg | 28–56 µL | 43 µL | 434 pmol | 43 µL |
| T-75 | 39.47 | 15 mL | 2 x 750 μL | 20–40 µg | 40–80 µL | 59 µL | 592 pmol | 59 µL |
| T-175 | 92.11 | 35 mL | 2 x 1.75 mL | 46–96 µg | 92–180 µL | 138 µL | 1,382 pmol | 138 µL |
* After determining the optimum reagent amount, use the multiplication factor to determine the reagent amount needed for your new plate format.
** Optimum amount needed is determined from the protocol for Lipofectamine 3000 Transfection Reagent.
For your convenience, the essential components of this protocol are now available in the Gibco Breast Cancer Starter Kit. The kit includes: basal medium, FBS, Lipofectamine 3000 reagent, Opti-MEM medium, and TrypLE reagent. The kit is available at thermofisher.com/cancercellculture. For additional components required for the protocol see ordering table below.
Find out more at thermofisher.com/3000
For Research Use Only. Not for use in diagnostic procedures.